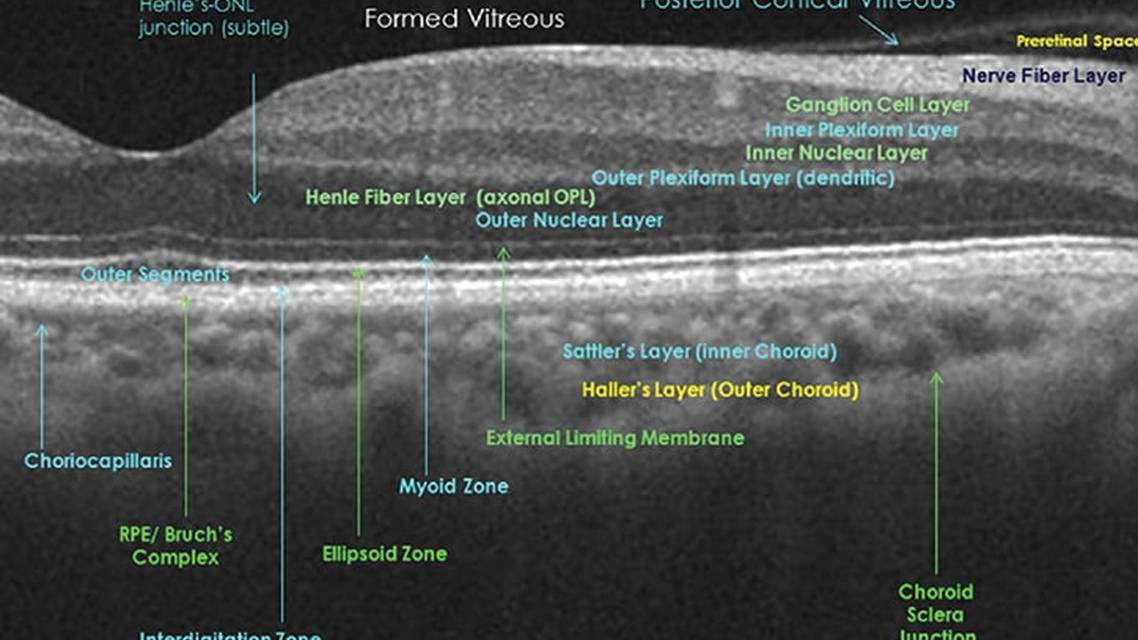
Optical Coherence Tomography and Neurology

Optical Coherence Tomography & Neurology
Visualization of baseline and serial images often provides direct evidence and biomarkers to challenge many preexisting “principles” in neurology, as is now possible with optical coherence tomography (OCT). Commercially available since 1993, OCT has achieved importance and significance equal to the ophthalmoscope. OCT makes the previously invisible structures of the retina and optic nerve visible at a 5- to 6-nm resolution in an imaging process that requires only 2 minutes per eye (Figure 1).

Understanding light reflectance enables comprehension of spectral domain OCT (SD-OCT) and multicolor OCT (MC-OCT). The surface reflectance of a material depends upon the ability of that material to return, or reflect, radiant energy to a viewing source. In the case of OCT, the materials are the optic disc, retina, and retinal blood vessels and the viewing source is the eye of the examiner. The electron structure of a material and the wavelength (frequency), angle of incidence, and any polarization of the light that illuminates the material also affect the final reflectance image.
In a manner identical to the ophthalmoscope, which created the now classic concept that the eye is the window to the brain for neurologic disease, so too has OCT expanded that window to make the deeper layers visible with a more precise view of the retinal arteries and veins in a painless, noncontact, noninvasive manner. In this context, it is not surprising that many clinical investigators believe OCT will become neurologists’ new ophthalmoscope, especially for outpatient care.
This article reviews 2 common clinical scenarios for which OCT has been validated for clinical neurologists: 1) remitting relapsing multiple sclerosis (RRMS) and optic neuritis and 2) neuromyelitis optica spectrum disorder (NMOSD). Although exciting basic and clinical trial research with OCT and metabolic imaging of the retina and optic disc for neurodegenerative disease are ongoing, these are beyond the scope of this article, which concentrates on practical clinical applications for neurologists and neuro-ophthalmologists.
Multiple Sclerosis and Optic Neuritis
Because of the unmyelinated axons emerging from retinal ganglion cells (RGCs) to form the optic nerve, OCT immediately attracted the attention of MS specialists and neuro-ophthalmologists to measure and monitor axonal loss. In some of the earliest histopathologic descriptions of MS, Charcot described not only demyelination of central nervous system (CNS) axons in the brain and spinal cord, but also axonal loss.
Immunohistochemistry studies also provide evidence of axonal loss in specimens from people with MS.1 This elegant and insightful work launched a vigorous search for ways to measure axonal loss in people with MS to obtain a comprehensive clinical assessment, especially as it relates to physical and cognitive disabilities, which ushered in the application of OCT for MS.2
For the first time, OCT provides the ability to measure loss of the retinal nerve fiber layer (RNFL) after optic neuritis or in people with MS who never have had clinically evident optic neuritis. Multiple studies with OCT demonstrate axonal loss in RRMS that correlate with clinical and MRI findings in MS.3,4 This work has shown that changes in the RGC layer may occur in RRMS coincident with an acute attack of optic neuritis or without a clinical event of optic neuritis.
As the resolution of OCT improved, it also proved capable of uncovering abnormalities in RGCs within the macula. RGCs are the source of the unmyelinated axons that will form the optic nerve and reach the lateral geniculate body as well as over 20 other regions in the brain.5 Correlations have emerged with regional brain volume measurements and the thickness of various retinal layers, although these studies are in the early stages.6
Although the current data are not yet well-enough validated to make a definitive diagnosis of RRMS without a complete neurologic examination and consistent MRI findings, OCT does provide a new, reliable, reproducible tool to track subclinical neurodegeneration (Table 1). In this context, it is helpful to remember that years and years of work were required before MRI was accepted as essential to the clinical care of patients and mandated in clinical trials.

Neuromyelitis Optica Spectrum Disorder
Contrary to strong opinions for many years, NMOSD does not represent severe MS. Until formative research discovered the aquaporins and the localization of aquaporin-4 at astrocytic footplates that tightly connect the CNS to retinal arterioles, NMOSD diagnosis was a monumental diagnostic challenge that often did not occur before blindness or paralysis ensued.
NMOSD represents a perfect example of how basic science research and precise immunopathologic correlations define a disease, enabling molecular diagnosis in many individuals with plasma aquaporin-4 antibody titers. Our newfound ability to diagnose NMOSD earlier than before, has enabled us to use OCT to show many individuals with the condition may present with not only the classic bilateral simultaneous optic neuritis but also with unilateral vision loss and optic neuritis (Table 2).7 SD-OCT studies have shown there is preferential loss of the inner nuclear layer of the retina in NMOSD, explaining the underlying dismal prognosis for visual recovery compared with clinically isolated syndrome (CIS) and RRMS. Following our previously mentioned paradigm of new imaging technologies solving unexplained medical observations, MC-OCT (Figure 2) has brought a new dimension of understanding to the visual loss in NMOSD plus retinal embolic disease.8,9


As shown in Figure 2, the innovation of MC-OCT is in using 3 different, simultaneous laser light wavelengths to produce “fundus photography tomograms” of the deep, mid, and inner retinal layers. Whereas ophthalmoscopes use white light with a wavelength of 400 nm, MC-OCT uses ultrared (815 nm), green (518 nm), and blue (486 nm) light to image the retina over almost the entire visible light spectrum. These different wavelengths create focused, detailed images of the retina to make the formerly invisible visible, especially the retinal blood vessels—making truly precision diagnostic medicine possible. MC-OCT is very sensitive for identifying small emboli within the retinal arterioles that are too small to see with the direct ophthalmoscope,8,9 leading to the definition of “microscopic Hollenhorst plaques” (Figure 3) that can differentiate embolic disease from giant cell arteritis, an incredibly valuable clinical tool. OCT can also reveal prior hypoperfusion through the central retinal artery that can result in irreversible damage to the retina and permanent loss of vision.

With the discovery of “microscopic Hollenhorst plaques,” it was also observed that those with NMOSD had green retinal arterioles on composite MC-OCT and white intravascular signals on green and blue reflectance images that are not seen in the outer retinal layer imaged with infrared light, because the retinal vasculature traverses both the green and blue reflectance zones but not the outer retinal layer. Individuals with NMOSD and devastating visual loss also have green signals in MC-OCT that are identical to embolic occlusions (Figure 4) that have also been found in Susac syndrome, a rare retinal vasculitis and sarcoidosis (Sergott, personal observations).

Therefore, in our experience many patients with devastating, permanent blindness in 1 or both eyes from NMOSD have inflammatory central retinal artery occlusions.9 Although visual symptoms may start initially with more involvement of RNFL, perhaps from demyelination, the coup de grace for permanent visual loss appears to be a retinal infarction, corresponding perfectly to the pathogenesis of the disease and histopathologic findings of strokes following severe cervical myelopathies.10 RNFL loss may also occur because of involvement of some of the very small branches of the central retinal artery in the retrobulbar optic nerve immediately posterior to the optic disc.11
The central retinal artery inflammatory occlusive process also explains the selective loss of the inner nuclear layers with SD-OCT because this area receives its vascular supply from the terminal capillaries of the branch retinal arterioles. In acute cases of NMOSD, the OCT finding of the “middle maculopathy syndrome” are also found, further confirming the vaso-occlusive pathophysiology of permanent blindness in this disease.12 Notably, until the advent of OCT, middle maculopathy was another syndrome that escaped detection.
Conclusion
Neuro-ophthalmic and retinal imaging of the optic nerve and retina with OCT has signficantly advanced since introduction into clinical practice. Improved image quality and reduced test-retest variability make OCT useful in both clinical practice and clinical trials in humans. Merging SD- and MC-OCT offers promise for differentiating RRMS from NMOSD as well as following disease activity and assessing therapeutic effects. Because of its truly “laser-focused” wavelength technology that focuses directly on retinal arterioles, MC-OCT improves diagnostic sensitivity for detecting emboli compared with standard ophthalmoscopy.
Ready to Claim Your Credits?
You have attempts to pass this post-test. Take your time and review carefully before submitting.
Good luck!